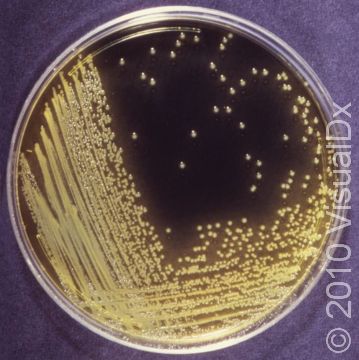
A bacterial culture plate tests positive for the bacterium Vibrio cholerae, the cause of cholera.

Cholera
Cholera is the name given to a diarrheal illness caused by the bacterium Vibrio cholerae. V. cholerae is found in water or food contaminated by feces. Cholera causes profuse watery diarrhea and can lead to death by sudden dehydration because of the tremendous output of liquid stool. You can contract cholera by eating or drinking food or water contaminated with feces containing V. cholerae. This same bacterium is also present in raw seafood, particularly shellfish.
The best way to avoid getting cholera is to be careful about what you eat or drink. When traveling to countries without clean drinking water, a good way to remember what foods and beverages are safe is to think: If you can not boil it (to kill bacteria), peel it (to remove bacteria), or cook it (to kill bacteria), do not eat it. Also when traveling, remember to avoid ice cubes, which may be made with contaminated water, and to check the seal on all bottled water that you purchase (as the water bottle may have been refilled with unclean water). Some travelers drink only carbonated water in order to avoid this issue.
How do I get cholera?
- By eating foods contaminated with feces containing V. cholerae
- By drinking water contaminated with feces containing V. cholerae
- By eating raw shellfish contaminated with V. cholerae
Who's At Risk?
Cholera is very rare in the United States; it is usually seen in underdeveloped areas of the world where the sewage systems are inadequate, such as Latin America, Asia, and Africa. Travelers to these countries (particularly children and the elderly) are at risk for contracting cholera. While cholera usually occurs in those who live in developed nations are traveling to underdeveloped areas, cholera is not the classic “travelers’ diarrhea.” That diarrhea is caused by E. coli species, discussed in a separate topic.
Signs & Symptoms
The hallmark of cholera is profuse watery grey-brown diarrhea; the diarrhea is sometimes described as “rice water diarrhea” because it can look like cloudy water with flecks of rice in it. The diarrhea begins hours to days after ingestion of the contaminated food or water and lasts 1–7 days. The affected person will complain of cramping abdominal pain; fatigue; and an overall weak, achy feeling (known as malaise). There is typically no blood in the diarrhea, and the affected person usually does not have a fever.
Symptoms of cholera include:
- Sudden onset of watery diarrhea
- Stool looks like water with flecks of rice in it
- Abdominal pain with cramps, nausea, and vomiting
- Dehydration with symptoms of dry mouth, sunken eyes, and rapid pulse (heart rate)
- Excessive thirst
- Sleepiness
- Decreased urine output
- In babies, sunken soft spots in the head (fontanelles)
Self-Care Guidelines
Stay hydrated, preferably with a liquid that contains some sugar and electrolytes, such as a sports drink. A person with cholera can lose up to a liter of fluid an hour, so if the diarrhea is severe, he/she should drink at least half a liter an hour. If nausea and vomiting prevent drinking fluids, intravenous (IV) fluid replacement will be necessary. Travelers to countries with cholera may want to pack a powdered electrolyte rehydration solution; be sure to use boiled water for reconstituting the solution. You may be tempted to take an anti-diarrheal drug such as loperamide, but if there is any blood in the diarrhea, check with your doctor first.
Drinking boiled skim milk is an old wives’ tale and can potentially cause very serious illness (in the form of hyponatremia, or dangerously low levels of salt in the body).
Treatments
Your doctor may prescribe an antibiotic to shorten the duration of symptoms. He or she may also collect a sample of your stool to test it for the presence of cells and bacteria; the results of these tests may guide the doctor’s choice of antibiotics. An oral vaccine has been shown to help provide short-term protection during outbreaks, although clean food and water are the best prevention.
Visit Urgency
See a doctor if the diarrhea lasts longer than a day or if you develop a high fever (ie, temperature greater than 39°C [102°F]). See a doctor immediately if you have any symptoms of dehydration, such as fainting or dizziness.
Trusted Links
Last modified on October 6th, 2022 at 2:49 pm

Not sure what to look for?
Try our new Rash and Skin Condition Finder